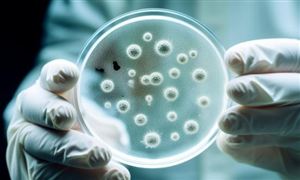

近年來,我國玻璃纖維產(chǎn)量保持增長趨勢。玻璃纖維是一種性能優(yōu)異的無機非金屬材料,玻璃纖維具有絕緣性好、耐熱性強、抗腐蝕性好、機械強度高等優(yōu)點,但缺點是性脆,耐磨性較差。它通常作為復(fù)合材料中的增強材料、電絕緣材料和絕熱保溫材料,以及電路基板等,廣泛應(yīng)用于建筑、航空航天、汽車、電子、船舶等國民經(jīng)濟各個領(lǐng)域。
它是以葉臘石、石英砂、石灰石、白云石、硼鈣石、硼鎂石六種礦石為原料經(jīng)高溫熔制、拉絲、絡(luò)紗、織布等工藝制造成的,其單絲的直徑為幾個微米到二十幾個微米,相當于一根頭發(fā)絲的 1/20-1/5 ,每束纖維原絲都由數(shù)百根甚至上千根單絲組成。玻璃纖維通常用作復(fù)合材料中的增強材料,電絕緣材料和絕熱保溫材料,電路基板等國民經(jīng)濟各個領(lǐng)域。
玻璃纖維行業(yè)發(fā)展現(xiàn)狀及競爭格局、進出口市場分析
玻璃纖維制品,整體市場需求增長不及預(yù)期。2023年我國玻璃纖維紗總產(chǎn)量達到723萬噸,同比增長5.2%,與2022 年相比增速回落5個百分點。受整體市場需求復(fù)蘇緩慢及產(chǎn)能供需持續(xù)失衡影響,自2023年以來行業(yè)多數(shù)在建或擬建池窯建設(shè)項目紛紛延遲投產(chǎn),巨石集團、重慶國際等企業(yè)在投產(chǎn)池窯新線的同時關(guān)停多條老線,部分球窯及中小坩堝拉絲生產(chǎn)企業(yè)則采取不同程度減產(chǎn)措施,促使行業(yè)整體在產(chǎn)產(chǎn)能規(guī)模在年內(nèi)實現(xiàn)由增轉(zhuǎn)降,玻纖紗總產(chǎn)量增速自下半年開始顯著放緩。
2023年我國玻璃纖維工業(yè)紗總產(chǎn)量為74.4萬噸,同比增長7.9%。除建筑用中堿網(wǎng)格布市場需求出現(xiàn)明顯下降外,各類工業(yè)用玻璃纖維氈布制品在建筑節(jié)能、道路土工、電氣絕緣、安全防護、環(huán)保過濾、化工防腐、裝飾裝修、農(nóng)牧養(yǎng)殖、戶外遮陽等諸多領(lǐng)域市場需求基本保持穩(wěn)中有增。其中,新能源及儲能建設(shè)、新能源汽車生產(chǎn)及各類生產(chǎn)生活用絕熱保溫、安全防護用各類工業(yè)織物制品,增速較快。通過與氣凝膠、石墨烯等新型材料復(fù)合,玻璃纖維工業(yè)織物制品不斷塑造新功能新優(yōu)勢,拓展新應(yīng)用新市場。
2024年一季度,受這些因素疊加外貿(mào)出口規(guī)模穩(wěn)中有增和國內(nèi)風電、光伏等新老細分市場穩(wěn)步增長的影響,玻璃纖維紗產(chǎn)量增速快速收窄,同比增速約為4.8%,其中3月單月玻纖紗同比增速僅為1.1%。從具體細分市場來看,工業(yè)用氈布制品方面,受房地產(chǎn)開發(fā)投資下降影響,建筑用玻纖制品細分市場繼續(xù)保持低迷;但受基礎(chǔ)設(shè)施投資增長帶動,各類土工、安全及電氣絕緣用玻纖制品細分市場持續(xù)升溫。電子用氈布制品方面,受移動手機、微型計算機、集成電路等產(chǎn)量增長影響,各類電子用玻纖氈布制品市場需求整體仍呈現(xiàn)穩(wěn)中有增態(tài)勢。玻纖增強復(fù)合材料制品方面,受風力發(fā)電裝機和汽車總產(chǎn)量增長影響,風電及汽車細分市場逐步回溫。
根據(jù)中研普華產(chǎn)業(yè)研究院發(fā)布的《2024-2029年中國玻璃纖維行業(yè)市場投資分析及供需格局預(yù)測報告》顯示:
在出口方面,玻璃纖維及制品在出口產(chǎn)品結(jié)構(gòu)方面呈現(xiàn)多樣化特點。商品紗、機織物、機械氈、化學氈、預(yù)浸料及其他制品等五大類產(chǎn)品均有出口。其中,玻璃纖維無捻粗紗、長度不超過50毫米的玻璃纖維短切原絲、玻璃纖維制化學結(jié)合氈等是出口量較大的產(chǎn)品。整體來看,出口市場在行業(yè)去庫存方面繼續(xù)發(fā)揮重要作用。在進口方面,隨著前期國內(nèi)玻纖產(chǎn)品價格的持續(xù)下滑,我國玻纖及制品進口規(guī)模大幅收窄,但部分高端玻纖制品市場仍依賴于進口。進口產(chǎn)品結(jié)構(gòu)方面與出口相似,但規(guī)模相對較小。
中國玻璃纖維行業(yè)集中度整體較高,市場已形成寡頭壟斷格局。其中,中國巨石、泰山玻纖及重慶國際等企業(yè)占據(jù)較大市場份額。這些企業(yè)憑借規(guī)模優(yōu)勢、成本優(yōu)勢或研發(fā)優(yōu)勢,在不同細分領(lǐng)域形成差異化定位格局。同時,外圍仍有產(chǎn)業(yè)資本在考慮進入玻璃纖維行業(yè),建設(shè)自己的玻璃纖維大型池窯拉絲生產(chǎn)基地,行業(yè)競爭將進一步加劇。
玻璃纖維及制品的價格受多種因素影響,包括供需關(guān)系、原材料價格、生產(chǎn)成本等。近年來,隨著行業(yè)供需形勢的改善和產(chǎn)品價格的整體觸底反彈,玻璃纖維紗及制品的價格逐步呈現(xiàn)回升態(tài)勢。特別是在2024年一季度,受供給端持續(xù)收縮和需求端穩(wěn)步增長的影響,產(chǎn)品價格實現(xiàn)觸底反彈。
隨著下游應(yīng)用領(lǐng)域的不斷拓展和升級,玻璃纖維行業(yè)將向高端化、智能化方向發(fā)展。具備行業(yè)領(lǐng)先技術(shù)、優(yōu)勢產(chǎn)品結(jié)構(gòu)、優(yōu)異品質(zhì)和服務(wù)的綜合性玻璃纖維企業(yè)將在競爭中脫穎而出。
在雙碳目標推動下,玻璃纖維行業(yè)將更加注重綠色化發(fā)展。通過采用環(huán)保材料、優(yōu)化生產(chǎn)工藝等方式降低能耗和減少排放,提高資源利用效率。隨著光伏、新能源汽車等新興市場的快速發(fā)展,玻璃纖維行業(yè)將迎來新的增長機遇。這些新興市場將帶動玻璃纖維需求的持續(xù)增長,并推動行業(yè)技術(shù)創(chuàng)新和產(chǎn)業(yè)升級。
綜上所述,玻璃纖維行業(yè)市場現(xiàn)狀呈現(xiàn)出產(chǎn)能穩(wěn)步增長、市場需求多樣化、進出口活躍、價格回升以及競爭格局集中等特點。未來,隨著行業(yè)向高端化、智能化和綠色化方向發(fā)展以及新興市場的快速增長,玻璃纖維行業(yè)將迎來更加廣闊的發(fā)展前景。
中研普華通過對市場海量的數(shù)據(jù)進行采集、整理、加工、分析、傳遞,為客戶提供一攬子信息解決方案和咨詢服務(wù),最大限度地幫助客戶降低投資風險與經(jīng)營成本,把握投資機遇,提高企業(yè)競爭力。想要了解更多最新的專業(yè)分析請點擊中研普華產(chǎn)業(yè)研究院的《2024-2029年中國玻璃纖維行業(yè)市場投資分析及供需格局預(yù)測報告》。

研究院服務(wù)號
研究院服務(wù)號
 中研網(wǎng)訂閱號
中研網(wǎng)訂閱號